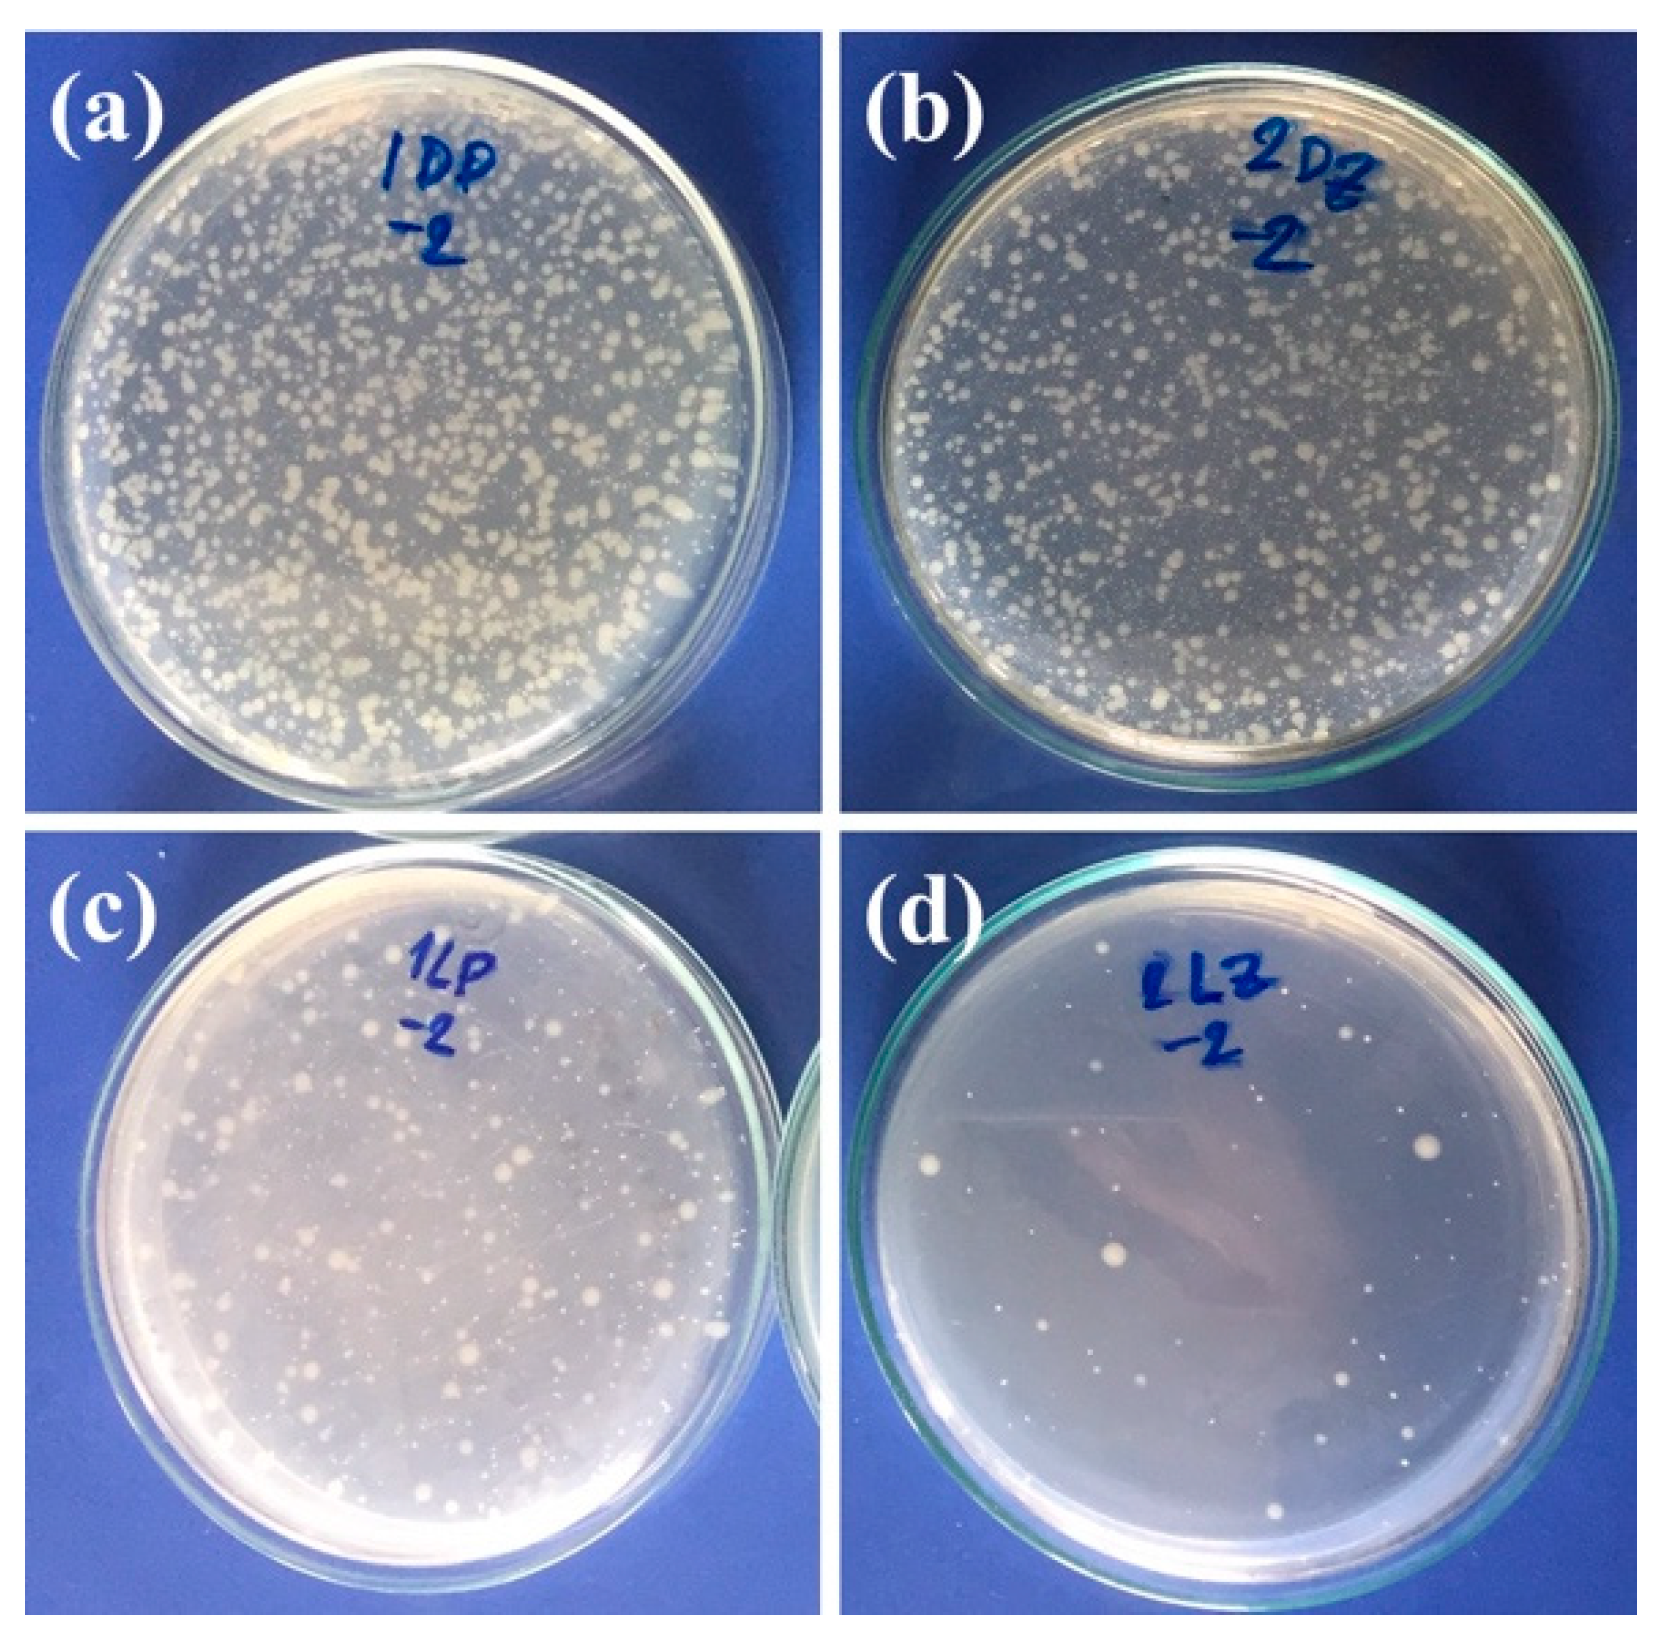
Materials 13 00914 g011

Polypropylene/ZnO Nanocomposites: Mechanical Properties, Photocatalytic Dye Degradation, and Antibacterial Property
Abstract
1. Introduction
2. Materials and Methods
2.1. Materials
2.2. Methods
2.2.1. Preparation of PP/ZnO Nanocomposite Materials
2.2.2. Characterizations of PP/ZnO Nanocomposite Materials
3. Results and Discussion
3.1. Characterizations of PP/ZnO Nanocomposites
3.2. Effect of Exposure to Sunlight on Mechanical Property and Chemical Structure Changes
3.2.1. Tensile Testing Result
3.2.2. FTIR Results
3.2.3. Photocatalytic Activity
3.2.4. Antibacterial Activity
4. Conclusions
Author Contributions
Funding
Acknowledgments
Conflicts of Interest
References
- Chawla, K.K. Composite Materials: Science and Engineering; Springer-Verlag: New York, USA, 2012. [Google Scholar]
- Bustos-Torres, K.A.; Vazquez-Rodriguez, S.; Martínez-de la Cruz, A.; Sepulveda-Guzman, S.; Benavides, R.; Lopez-Gonzalez, R.; Torres-Martínez, L.M. Influence of the morphology of ZnO nanomaterials on photooxidation of polypropylene/ZnO composites. Mater. Sci. Semicond. Process. 2017, 68, 217–225. [Google Scholar] [CrossRef]
- Yemmireddy, V.K.; Hung, Y.C. Using photocatalyst metal oxides as antimicrobial surface coatings to ensure food safety—Opportunities and challenges. Compr. Rev. Food Sci. Food Saf. 2017, 16, 617–631. [Google Scholar] [CrossRef]
- Silvestre, C.; Duraccio, D.; Marra, A.; Strongone, V.; Cimmino, S. Development of antibacterial composite films based on isotactic polypropylene and coated ZnO particles for active food packaging. Coatings 2016, 6, 4. [Google Scholar] [CrossRef]
- Silvestre, C.; Duraccio, D.; Cimmino, S. Food packaging based on polymer nanomaterials. Prog. Polym. Sci. 2011, 36, 1766–1782. [Google Scholar] [CrossRef]
- Rtimi, S.; Dionysiou, D.D.; Pillai, S.C.; Kiwi, J. Advances in catalytic/photocatalytic bacterial inactivation by nano Ag and Cu coated surfaces and medical devices. Appl. Catal. B Environ. 2019, 240, 291–318. [Google Scholar] [CrossRef]
- Gabriel, G.J.; Som, A.; Madkour, A.E.; Eren, T.; Tew, G.N. Infectious disease: Connecting innate immunity to biocidal polymers. Mater. Sci. Eng. R Rep. 2007, 57, 28–64. [Google Scholar] [CrossRef]
- Colmenares, J.C.; Kuna, E.; Jakubiak, S.; Michalski, J.; Kurzydłowski, K. Polypropylene nonwoven filter with nanosized ZnO rods: Promising hybrid photocatalyst for water purification. Appl. Catal. B Environ. 2015, 170, 273–282. [Google Scholar] [CrossRef]
- Yang, R.; Christensen, P.; Egerton, T.; White, J. Degradation products formed during UV exposure of polyethylene–ZnO nano-composites. Polym. Degrad. Stab. 2010, 95, 1533–1541. [Google Scholar] [CrossRef]
- Romero Saez, M.; Jaramillo, L.; Saravanan, R.; Benito, N.; Pabón, E.; Mosquera, E.; Gracia Caroca, F. Notable photocatalytic activity of TiO2-polyethylene nanocomposites for visible light degradation of organic pollutants. Express Polym. Lett. 2017. [Google Scholar] [CrossRef]
- Curcio, M.S.; Canela, M.C.; Waldman, W.R. Selective surface modification of TiO2-coated polypropylene by photodegradation. Eur. Polym. J. 2018, 101, 177–182. [Google Scholar] [CrossRef]
- Zaman, H.U.; Hun, P.D.; Khan, R.A.; Yoon, K.-B. Morphology, mechanical, and crystallization behaviors of micro-and nano-ZnO filled polypropylene composites. J. Reinf. Plast. Compos. 2012, 31, 323–329. [Google Scholar] [CrossRef]
- Erem, A.D.; Ozcan, G.; Skrifvars, M. In vitro assessment of antimicrobial polypropylene/zinc oxide nanocomposite fibers. Text. Res. J. 2013, 83, 2152–2163. [Google Scholar] [CrossRef]
- Chu, Z.; Zhao, T.; Li, L.; Fan, J.; Qin, Y. Characterization of antimicrobial poly (lactic acid)/nano-composite films with silver and zinc oxide nanoparticles. Materials 2017, 10, 659. [Google Scholar] [CrossRef] [PubMed]
- Jamnongkan, T.; Sukumaran Sathish, K.; Sugimoto, M.; Hara, T.; Takatsuka, Y.; Koyama, K. Towards novel wound dressings: Antibacterial properties of zinc oxide nanoparticles and electrospun fiber mats of zinc oxide nanoparticle/poly(vinyl alcohol) hybrids. J. Polym. Eng. 2015, 35, 575. [Google Scholar] [CrossRef]
- Im, Y.M.; Oh, T.H.; Nathanael, J.A.; Jang, S.S. Effect of ZnO nanoparticles morphology on UV blocking of poly (vinyl alcohol)/ZnO composite nanofibers. Mater. Lett. 2015, 147, 20–24. [Google Scholar] [CrossRef]
- Zhao, H.; Li, R.K. A study on the photo-degradation of zinc oxide (ZnO) filled polypropylene nanocomposites. Polymer 2006, 47, 3207–3217. [Google Scholar] [CrossRef]
- Eskizeybek, V.; Sarı, F.; Gülce, H.; Gülce, A.; Avcı, A. Preparation of the new polyaniline/ZnO nanocomposite and its photocatalytic activity for degradation of methylene blue and malachite green dyes under UV and natural sun lights irradiations. Appl. Catal. B Environ. 2012, 119, 197–206. [Google Scholar] [CrossRef]
- De Silva, R.T.; Pasbakhsh, P.; Lee, S.M.; Kit, A.Y. ZnO deposited/encapsulated halloysite–poly (lactic acid) (PLA) nanocomposites for high performance packaging films with improved mechanical and antimicrobial properties. Appl. Clay Sci. 2015, 111, 10–20. [Google Scholar] [CrossRef]
- Fa, W.; Yang, C.; Gong, C.; Peng, T.; Zan, L. Enhanced photodegradation efficiency of polyethylene-TiO2 nanocomposite film with oxidized polyethylene wax. J. Appl. Polym. Sci. 2010, 118, 378–384. [Google Scholar] [CrossRef]
- Sirelkhatim, A.; Mahmud, S.; Seeni, A.; Kaus, N.H.M.; Ann, L.C.; Bakhori, S.K.M.; Hasan, H.; Mohamad, D. Review on zinc oxide nanoparticles: Antibacterial activity and toxicity mechanism. Nano Micro Lett. 2015, 7, 219–242. [Google Scholar] [CrossRef]
- Colon, G.; Ward, B.C.; Webster, T.J. Increased osteoblast and decreased Staphylococcus epidermidis functions on nanophase ZnO and TiO2. J. Biomed. Mater. Res. A 2006, 78, 595–604. [Google Scholar] [CrossRef] [PubMed]
- Zhang, J. Silver-coated zinc oxide nanoantibacterial synthesis and antibacterial activity characterization. In Proceedings of the 2011 International Conference on Electronics and Optoelectronics, Liaoning, China, 29–31 July 2011. [Google Scholar] [CrossRef]
- Yang, Y.; Chen, H.; Zhao, B.; Bao, X. Size control of ZnO nanoparticles via thermal decomposition of zinc acetate coated on organic additives. J. Cryst. Growth 2004, 263, 447–453. [Google Scholar] [CrossRef]
- Sato, T.; Tanigaki, T.; Suzuki, H.; Saito, Y.; Kido, O.; Kimura, Y.; Kaito, C.; Takeda, A.; Kaneko, S. Structure and optical spectrum of ZnO nanoparticles produced in RF plasma. J. Cryst. Growth 2003, 255, 313–316. [Google Scholar] [CrossRef]
- Yang, Y.; Wu, M.; Zhu, X.; Xu, H.; Ma, S.; Zhi, Y.; Xia, H.; Liu, X.; Pan, J.; Tang, J.-Y.; et al. 2020 Roadmap on two-dimensional nanomaterials for environmental catalysis. Chin. Chem. Lett. 2019, 30, 2065–2088. [Google Scholar] [CrossRef]
- Sawai, J. Quantitative evaluation of antibacterial activities of metallic oxide powders (ZnO, MgO and CaO) by conductimetric assay. J. Microbiol. Methods 2003, 54, 177–182. [Google Scholar] [CrossRef]
- Seil, J.T.; Taylor, E.N.; Webster, T.J. Reduced activity of Staphylococcus epidermidis in the presence of sonicated piezoelectric zinc oxide nanoparticles. In Proceedings of the 2009 IEEE 35th Annual Northeast Bioengineering Conference, Boston, MA, USA, 3–5 April 2009; pp. 1–2. [Google Scholar]
- Weather Online. Available online: www.weatheronline.co.uk/html (accessed on 10 January 2020).
- Sanitnon, P.; Chiarakorn, S.; Chawengkijwanich, C.; Chuangchote, S.; Pongprayoon, T. Synergistic effects of zirconium and silver co-dopants in TiO2 nanoparticles for photocatalytic degradation of an organic dye and antibacterial activity. J. Aust. Ceram. Soc. 2019, 1–12. [Google Scholar] [CrossRef]
- Bacteriological Analytical Manual Online, Chapter 4: Enumeration of Escherichia coli and the coliform bacteria, USFDA, 10 pp. Available online: http://www.cfsan.fda.gov (accessed on 10 January 2020).
- Buzea, C.; Pacheco, I.I.; Robbie, K. Nanomaterials and nanoparticles: Sources and toxicity. Biointerphases 2007, 2, MR17. [Google Scholar] [CrossRef]
- Jiang, J.; Li, G.; Ding, Q.; Mai, K. Ultraviolet resistance and antimicrobial properties of ZnO-supported zeolite filled isotactic polypropylene composites. Polym. Degrad. Stab. 2012, 97, 833–838. [Google Scholar] [CrossRef]
- Karami, Z.; Youssefi, M.; Borhani, S. The effects of UV irradiation exposure on the structure and properties of polypropylene/ZnO nanocamposite fibers. Fibers Polym. 2013, 14, 1627–1634. [Google Scholar] [CrossRef]
- Senatova, S.; Senatov, F.; Kuznetsov, D.; Stepashkin, A.; Issi, J. Effect of UV-radiation on structure and properties of PP nanocomposites. J. Alloy. Compd. 2017, 707, 304–309. [Google Scholar] [CrossRef]
- Jung, M.R.; Horgen, F.D.; Orski, S.V.; Rodriguez, V.; Beers, K.L.; Balazs, G.H.; Jones, T.T.; Work, T.M.; Brignac, K.C.; Royer, S.-J. Validation of ATR FT-IR to identify polymers of plastic marine debris, including those ingested by marine organisms. Mar. Pollut. Bull. 2018, 127, 704–716. [Google Scholar] [CrossRef] [PubMed]
- Gutiérrez-Villarreal, M.H.; Zavala-Betancourt, S.A. A comparative study of the photodegradation of two series of cyclic olefin copolymers. Int. J. Polym. Sci. 2017, 2017. [Google Scholar] [CrossRef]
- Talebian, N.; Nilforoushan, M. Comparative study of the structural, optical and photocatalytic properties of semiconductor metal oxides toward degradation of methylene blue. Thin Solid Film. 2010, 518, 2210–2215. [Google Scholar] [CrossRef]
- Zhang, H.; Chen, B.; Jiang, H.; Wang, C.; Wang, H.; Wang, X. A strategy for ZnO nanorod mediated multi-mode cancer treatment. Biomaterials 2011, 32, 1906–1914. [Google Scholar] [CrossRef]
- Weng, B.; Qi, M.-Y.; Han, C.; Tang, Z.-R.; Xu, Y.-J. Photocorrosion inhibition of semiconductor-based photocatalysts: Basic principle, current development, and future perspective. ACS Catal. 2019, 9, 4642–4687. [Google Scholar] [CrossRef]
- Luo, Y.; Xu, N.; Liu, X.; Yang, L.; Wu, H.; Qin, Y. Photoactivity enhanced and photo-corrosion inhibited Ag3PO4/ZnO visible light photocatalyst for the degradation of Rhodamine B. Energy Environ. Focus 2015, 4, 121–127. [Google Scholar] [CrossRef]
- Di Mauro, A.; Cantarella, M.; Nicotra, G.; Pellegrino, G.; Gulino, A.; Brundo, M.V.; Privitera, V.; Impellizzeri, G. Novel synthesis of ZnO/PMMA nanocomposites for photocatalytic applications. Sci. Rep. 2017, 7, 40895. [Google Scholar] [CrossRef]
- Guo, B.-L.; Han, P.; Guo, L.-C.; Cao, Y.-Q.; Li, A.-D.; Kong, J.-Z.; Zhai, H.-F.; Wu, D. The antibacterial activity of Ta-doped ZnO nanoparticles. Nanoscale Res. Lett. 2015, 10, 336. [Google Scholar] [CrossRef]

© 2020 by the authors. Licensee MDPI, Basel, Switzerland. This article is an open access article distributed under the terms and conditions of the Creative Commons Attribution (CC BY) license (http://creativecommons.org/licenses/by/4.0/).
Share and Cite
Prasert, A.; Sontikaew, S.; Sriprapai, D.; Chuangchote, S. Polypropylene/ZnO Nanocomposites: Mechanical Properties, Photocatalytic Dye Degradation, and Antibacterial Property. Materials 2020, 13, 914. https://doi.org/10.3390/ma13040914
Prasert A, Sontikaew S, Sriprapai D, Chuangchote S. Polypropylene/ZnO Nanocomposites: Mechanical Properties, Photocatalytic Dye Degradation, and Antibacterial Property. Materials. 2020; 13(4):914. https://doi.org/10.3390/ma13040914
Chicago/Turabian StylePrasert, Ampawan, Somchoke Sontikaew, Dilok Sriprapai, and Surawut Chuangchote. 2020. "Polypropylene/ZnO Nanocomposites: Mechanical Properties, Photocatalytic Dye Degradation, and Antibacterial Property" Materials 13, no. 4: 914. https://doi.org/10.3390/ma13040914
APA StylePrasert, A., Sontikaew, S., Sriprapai, D., & Chuangchote, S. (2020). Polypropylene/ZnO Nanocomposites: Mechanical Properties, Photocatalytic Dye Degradation, and Antibacterial Property. Materials, 13(4), 914. https://doi.org/10.3390/ma13040914

